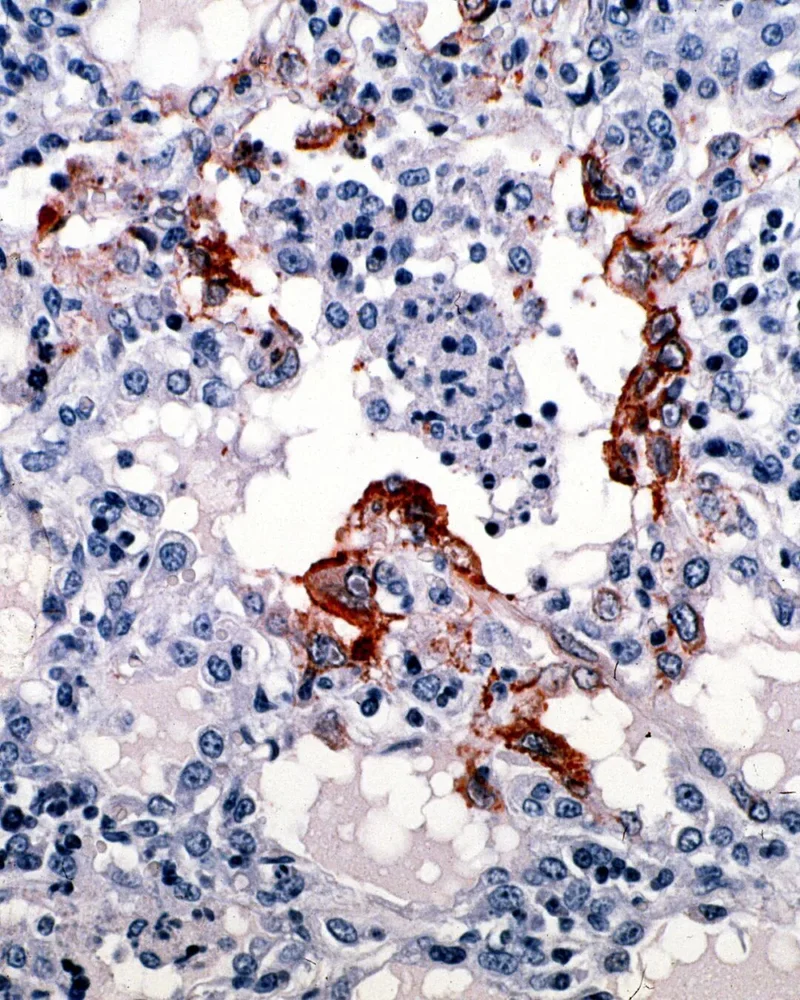

来源:地球知识局/央视
于 2026年01月27日 08:08
》〉》返回首页
最近,在印度东部的西孟加拉邦,有两名护士出现了不寻常的症状——高热、呼吸困难、意识混乱。经过进一步检测、诊断,发现这并不是一种寻常疾病,而是一种致死率极高、能人传人的新型病毒——尼帕病毒。其实在过去十余年间
已经不止一次在印度境内检测到该病毒▼

目前印度确诊了至少5例,还没有患者死亡,但最初确诊的两名护士中,有一名处在极危状态。
这种病毒的恐怖之处在于,患者会在呼吸困难、抽搐中,清醒地大脑在失控,语言、记忆、判断力一项项消失,最后陷入深度昏迷。而医护人员只能束手无策。
可怕的尼帕病毒长这样(红色部分)
(图:壹图网)▼

那么,这种病毒会不会传播到中国?会不会是新冠2.0呢?
自然宿主是果蝠
尼帕病毒对很多人来说,可能还很陌生,但如果你去问做传染病、病毒学或公共卫生的人,他们大多会给出一个相同的评价:这是一种高风险病毒。它长期被世界卫生组织列入“重点监测的新发传染病清单”。
世界卫生组织在其“关键事实”中对尼帕病毒的描述非常直接——“可引起一系列临床表现,从无症状感染(亚临床)到急性呼吸道感染和致命性脑炎。”
轻则头痛发烧,重则呼吸困难乃至昏迷
并且还可能留下神经系统或脑部的后遗症
(图:who.int)▼

从病毒分类上看,尼帕病毒属于人畜共患病,它原本并不是“为人类准备的”,其自然宿主是果蝠,尤其是狐蝠这一类大型果蝠。在果蝠体内,尼帕病毒却并不引发明显症状。这恰恰是自然宿主最典型的状态——病毒和宿主之间达成了某种“和平共处”。
问题出在跨物种传播。一旦尼帕病毒通过污染的食物、动物中间宿主,或者直接接触,进入人体,事情就完全变了。它几乎不走“温和路线”,而是直接攻击两个生命系统的核心。
果蝠:啊对对对,又是我
(图:壹图网)▼

第一个是呼吸系统。病毒侵入后,可迅速引发肺炎,患者会出现持续发热、剧烈咳嗽、呼吸困难,影像学检查往往能看到肺部广泛受累。
在重症情况下,会发展为急性呼吸窘迫综合征,需要依赖呼吸机维持氧合。这也是很多患者早期被送进 ICU 的原因之一。
棕色部分即为侵扰肺部的尼帕病毒
这种感染势必会对呼吸系统造成影响
(图:Wikimedia Commons)▼
但真正让尼帕病毒“名声在外”的,是它对中枢神经系统的攻击能力。病毒可以穿越血脑屏障,引发脑炎。临床上常见的表现包括意识障碍、抽搐、昏迷,进展速度很快。有些患者在短时间内就会从发热头痛,发展到深度昏迷。
尼帕脑炎患者的脑部病灶(白色部分)
(图:ajronline.org)▼

即便幸运地活了下来,仍有相当比例的幸存者在康复后出现癫痫等长期神经系统后遗症。世界卫生的调查报告,以及多项随访研究都明确提到,尼帕病毒感染的“远期神经损伤”问题不容忽视。
和埃博拉病毒同级别
说到这里,很多人会下意识问一句:医生有没有什么“对症的狠药”?
遗憾的是,没有。
到目前为止,尼帕病毒依然没有获批的特异性抗病毒治疗方案,也没有上市的疫苗。
最近,中国科学院武汉病毒研究所,联合上海药物研究所、旺山旺水生物医药股份有限公司发表了一项重要研究成果,证实口服核苷类药物VV116对尼帕病毒具有显著的抗病毒活性。
中国科研团队在《新兴微生物与感染》发表的论文

虽然这项研究成果为防治带来新希望,但是从科研、新药获批到上市,还有很长一段路要走。而目前临床所能做的事情,只有尽量托住患者。
托住呼吸,托住循环,控制并发症,防止继发感染,密切监护神经系统状态。这就是所谓的“支持治疗”。
针对尼帕病毒的抗体药物和疫苗仍在研发中
(尼帕病毒感染患者,图:gazettengr.com)▼

在医学上,这种治疗方式本身并不等于无效,但它有一个前提——患者本身得有挺过去的生理基础。一旦病毒破坏过快、过猛,医生能干预的空间就会迅速变小。
也正因为如此,尼帕病毒的致死率始终居高不下。根据世界卫生组织汇总的多次疫情数据,大多数尼帕病毒疫情中的病死率在40%到75%之间浮动。在某些单次疫情中,病死率甚至高达100%。这已经稳稳站在全球高致死率病毒的第一梯队了。
在生物安全等级中,尼帕病毒属于最高的四级,和埃博拉病毒是一个级别。
这也就是为什么,一旦出现确诊病例,公共卫生系统的反应必须极快。隔离不是“建议”,而是硬措施;密切接触者追踪也不是走流程,而是和时间赛跑。
处理死亡的感染者时也必须十分小心
(图:chosun.com)▼

因为尼帕病毒确实存在人传人的情况,尤其是在家庭照护和医疗环境中,这一点在孟加拉国和印度过往疫情中已经被反复证实。
从预防角度来说,尼帕病毒并不算“花样很多”。核心原则其实很朴素:切断它最常见的传播路径。避免接触果蝠及其分泌物,不食用可能被果蝠污染的食物,比如在部分地区流行的生椰枣汁。
提取椰枣汁的切口及容器可能被果蝠的唾液或粪便污染
不经过煮沸消毒而直接饮用,就有可能染上病毒
(图:壹图网)▼

在疫情发生区域,严格执行手卫生和防护措施,降低人际传播风险。这些建议在 WHO 的公共卫生指南中都有明确说明。
也正因为风险清晰,周边国家的反应相当迅速。疫情通报后,与西孟加拉邦接壤的尼泊尔很快加强了机场和陆路口岸的检疫监测。
与此同时,由于当时有大量印度游客前往泰国旅游,普吉国际机场也同步提高了对来自印度旅客的健康筛查级别。
在曼谷的两座机场
泰国疾控部门加强了对印度旅客的筛查
(图:independent.co.uk)▼

这种反应并不是“过度紧张”,而是典型的传染病防控思路——宁可早一步,也不要晚一步。
其实,这并不是尼帕病毒第一次登上人类舞台。1999 年,它首次在马来半岛的养猪场被确认。果蝠先将病毒传播给猪,猪作为中间宿主放大了病毒规模,随后与感染猪密切接触的人群大量染病。
为了防止疫情进一步扩散爆发
马来西亚政府最终扑杀了近百万头猪
(图:npr.org)▼

那次疫情,由于一开始被误诊为乙型脑炎,最后导致约300人感染,100多人死亡。
会传播到中国吗?
到目前为止,报告过尼帕病毒人类病例的国家包括马来西亚、新加坡、菲律宾、孟加拉国和印度。
一旦发现相关病例
公共卫生机构和医护系统人员必须快速行动起来
(图:X)▼

真正让人警惕的地方在于:虽然报告病例的国家有限,但果蝠的分布并不有限。
携带尼帕病毒的果蝠广泛分布于南亚、东南亚、中国南方(包括云南、贵州、广西、广东、福建等地),以及南太平洋和澳大利亚等地区。
这也是为什么“它会不会传到中国”这个问题,总会被反复提起。
从现有证据来看,中国南方确实存在果蝠种群,但目前尚不明确是否携带过活跃传播状态下的尼帕病毒。
世界卫生组织在综合评估后认为,在与印度相邻的国家之间,跨境传播的可能性是存在的,但在全球范围内,尼帕病毒形成大规模传播的风险,目前仍然较低。
作为与印度接壤的国家,我们不能掉以轻心
(中印边境,图:壹图网)▼

尼帕病毒虽然不是“新冠 2.0”,不具备那种悄无声息席卷全球的传播效率;但它也绝对不是可以被忽视的小麻烦。一旦感染,后果极重,医疗干预空间有限,对公共卫生体系的要求极高。
记者今天从国家疾控局了解到,本次印度暴发的尼帕病毒病疫情,主要发生在西孟加拉邦,与我国没有领土接壤。尼帕病毒病主要通过直接接触感染的动物、病人及污染物传播,病毒环境存活力弱,一般民众接触感染机会较少。综合研判,此次印度尼帕病毒病疫情对我国产生的影响相对较小。目前,我国尚未发现尼帕病毒病病例。但也存在一定境外输入风险,需加强防范。(总台央视记者杨阳 史迎春)